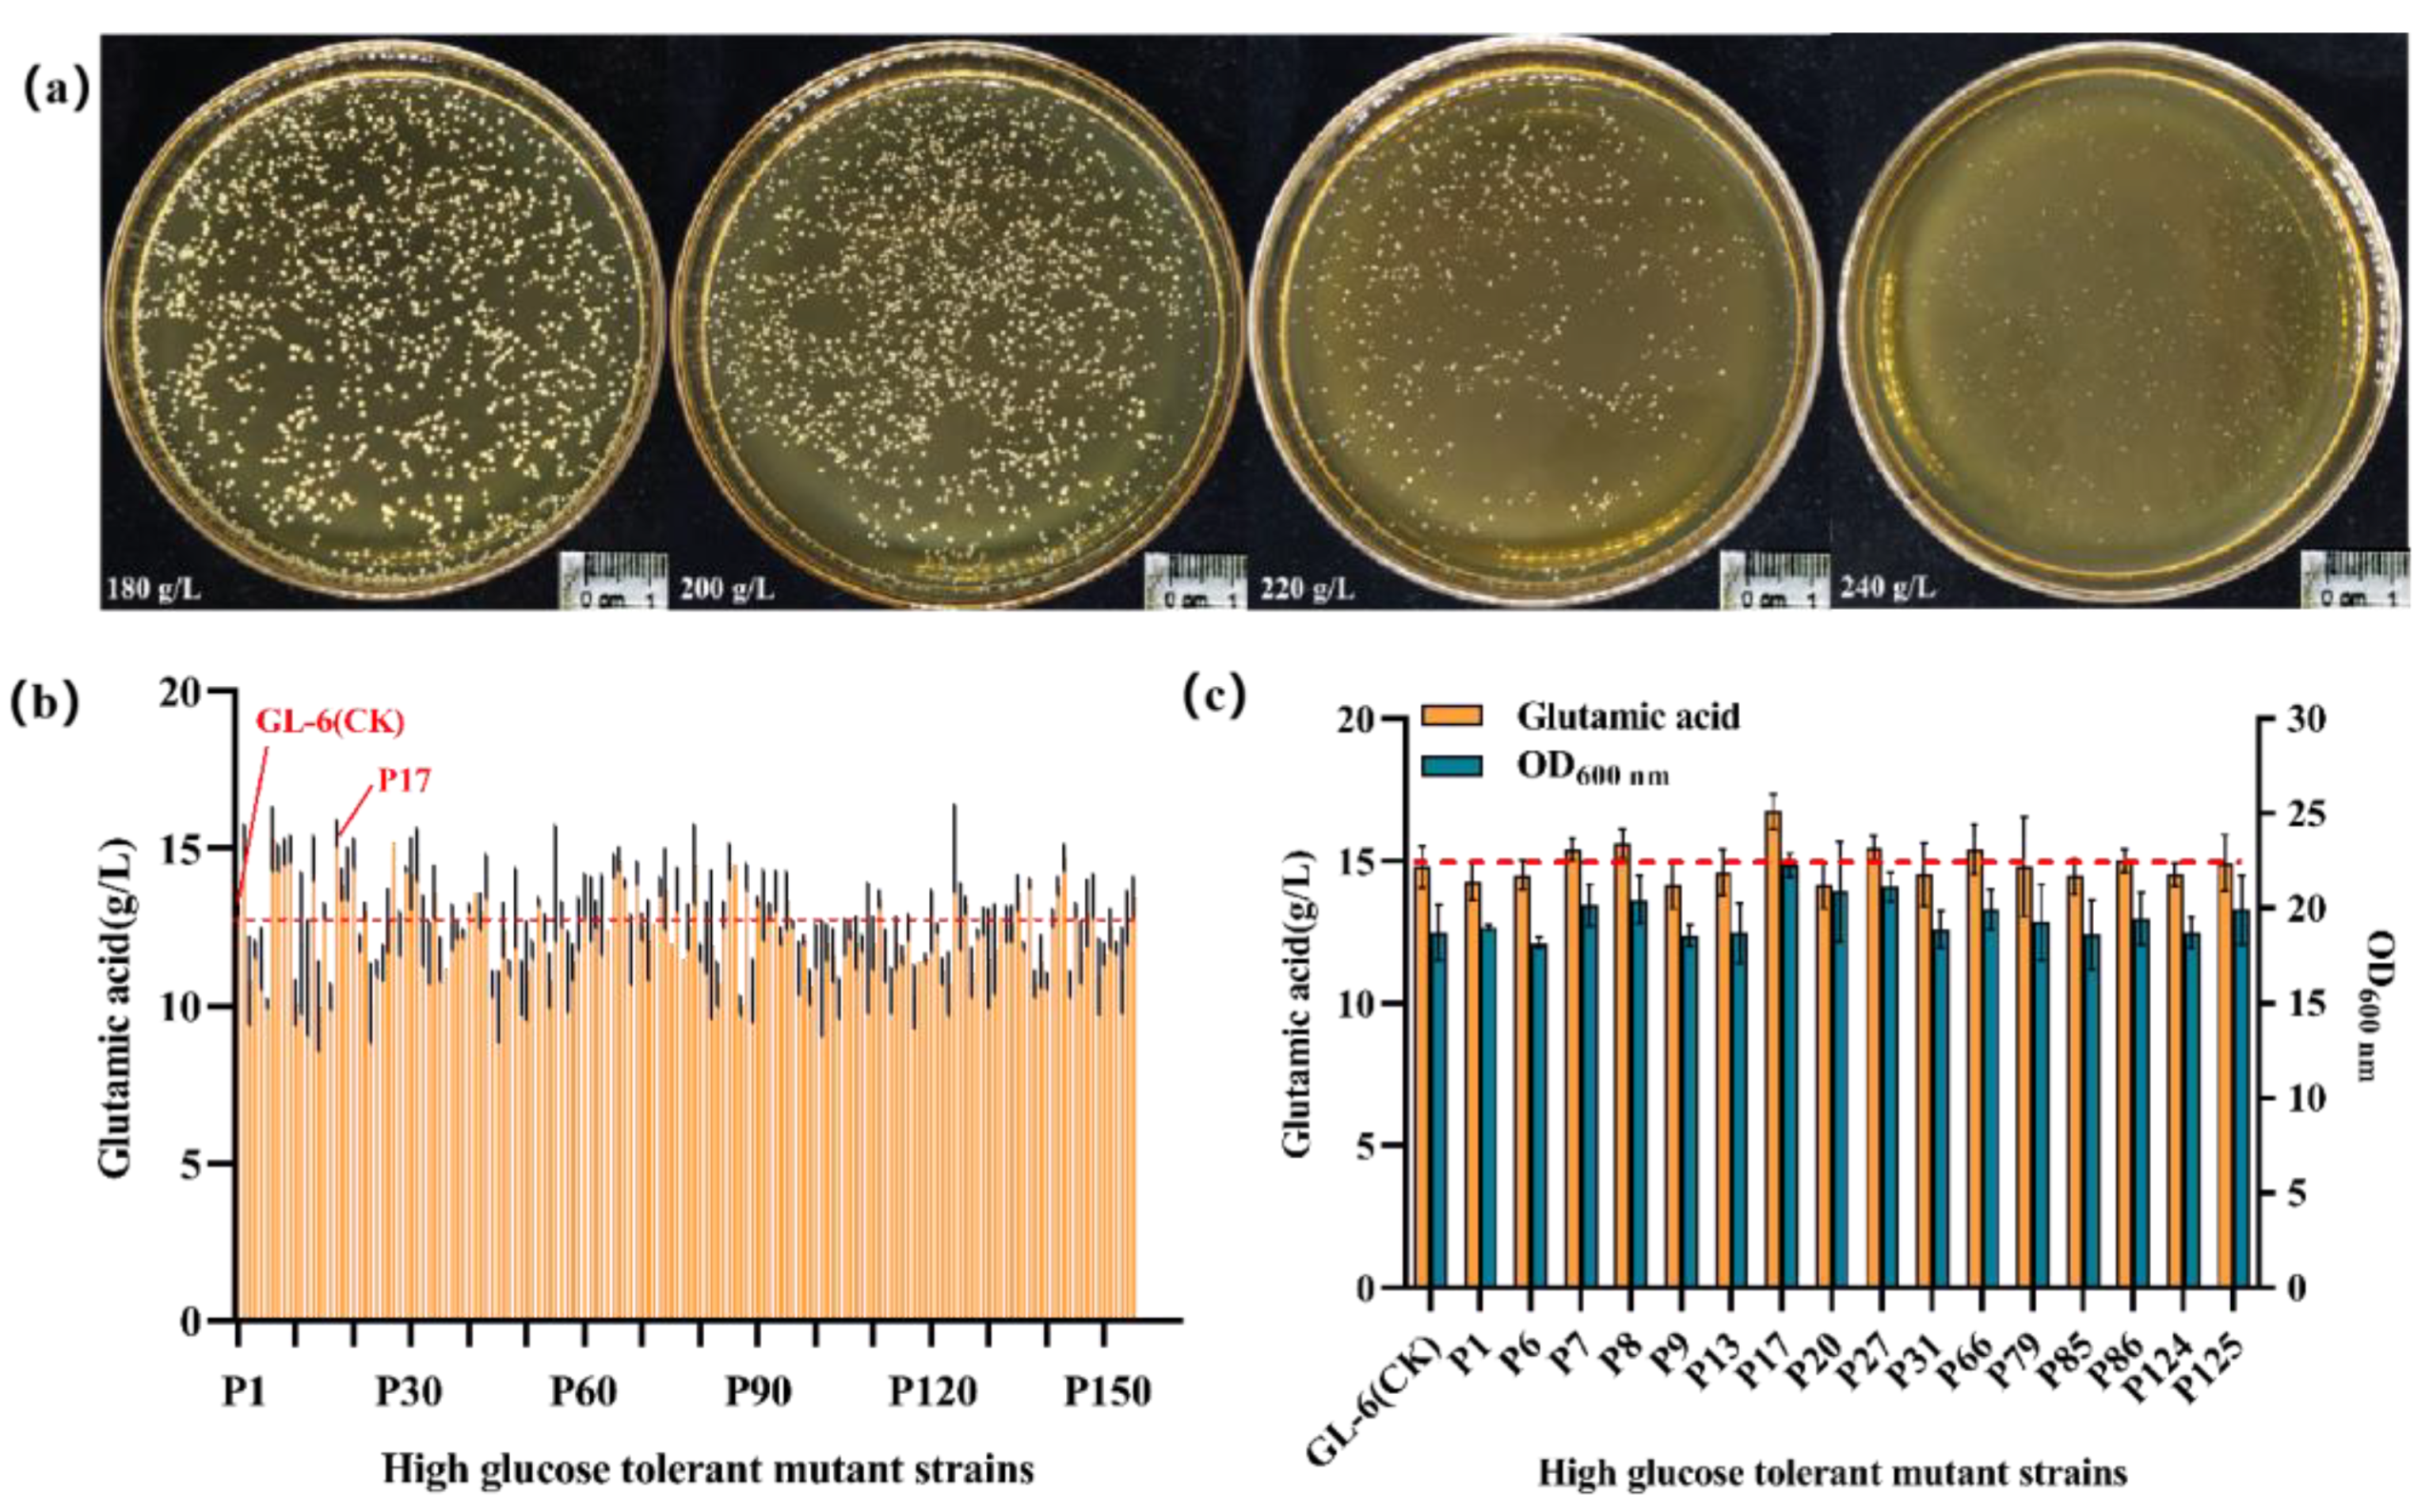
Fermentation 09 00599 g003

Improved Glutamic Acid Production Capacity of Corynebacterium glutamicum by the ARTP Mutagenesis Method
Abstract
1. Introduction
2. Materials and Methods
2.1. Microbiological Cultivation
2.2. ARTP Mutagenesis
2.3. Mutant Strain Screening
2.4. qRT-PCR Assay
2.5. 20 L Fermenter with Fed-Batch Fermentation
2.6. Analysis Method
2.7. Data Analysis
3. Results and Discussion
3.1. Determining the Optimal Time for Mutagenesis
3.2. Mutant Strain Screening
3.2.1. Mutant Strain Primary Screening
3.2.2. Cross-Iterative Mutagenic Strain Re-Screening
3.3. qRT-PCR Analysis
3.4. Comparison of Erlenmeyer Flasks Fermentation Processes
3.5. 20 L Fermenter with Fed-Batch Fermentation
4. Conclusions
Author Contributions
Funding
Institutional Review Board Statement
Informed Consent Statement
Data Availability Statement
Conflicts of Interest
Appendix A
| Number | Glutamic Acid Concentration (g/L) | Positive and Negative Mutations | Number | Glutamic Acid Concentration (g/L) | Positive and Negative Mutations |
|---|---|---|---|---|---|
| GL−6 | 12.7 ± 0.7 | CK | P78 | 12.5 ± 0.7 | − |
| P1 | 15.2 ± 0.6 | + | P79 | 14.1 ± 0.6 | + |
| P2 | 10.8 ± 1.4 | − | P80 | 11.7 ± 0.3 | − |
| P3 | 11.8 ± 0.3 | − | P81 | 12.2 ± 1.1 | − |
| P4 | 11.5 ± 1.0 | − | P82 | 12.0 ± 2.3 | − |
| P5 | 10.1 ± 0.1 | − | P83 | 10.7 ± 0.7 | − |
| P6 | 15.3 ± 1.0 | + | P84 | 12.9 ± 0.4 | + |
| P7 | 14.7 ± 0.4 | + | P85 | 14.2 ± 0.0 | + |
| P8 | 14.9 ± 0.4 | + | P86 | 14.0 ± 0.0 | + |
| P9 | 15.0 ± 0.4 | + | P87 | 10.0 ± 0.3 | − |
| P10 | 10.1 ± 0.7 | − | P88 | 14.1 ± 0.4 | + |
| P11 | 12.0 ± 2.3 | − | P89 | 10.5 ± 1.0 | − |
| P12 | 10.9 ± 1.8 | − | P90 | 13.3 ± 0.1 | + |
| P13 | 14.7 ± 0.7 | + | P91 | 13.2 ± 1.1 | + |
| P14 | 10.0 ± 1.4 | − | P92 | 13.0 ± 0.3 | − |
| P15 | 13.0 ± 0.3 | + | P93 | 13.7 ± 0.6 | + |
| P16 | 10.3 ± 0.4 | − | P94 | 12.2 ± 0.3 | − |
| P17 | 12.3 ± 0.7 | + | P95 | 13.4 ± 0.9 | + |
| P18 | 13.9 ± 0.5 | + | P96 | 12.6 ± 0.1 | − |
| P19 | 14.2 ± 0.9 | + | P97 | 11.2 ± 0.9 | − |
| P20 | 14.9 ± 0.5 | + | P98 | 12.1 ± 0.1 | − |
| P21 | 12.0 ± 0.3 | − | P99 | 10.6 ± 0.6 | − |
| P22 | 13.0 ± 0.3 | + | P100 | 11.9 ± 0.7 | − |
| P23 | 10.1 ± 1.3 | − | P101 | 10.9 ± 1.8 | − |
| P24 | 11.2 ± 0.3 | − | P102 | 12.0 ± 0.6 | − |
| P25 | 11.4 ± 0.6 | − | P103 | 11.6 ± 0.9 | − |
| P26 | 12.7 ± 1.0 | / | P104 | 10.3 ± 0.6 | − |
| P27 | 15.2 ± 0.0 | + | P105 | 12.2 ± 0.6 | − |
| P28 | 15.6 ± 0.4 | + | P106 | 12.4 ± 0.3 | − |
| P29 | 14.4 ± 0.1 | + | P107 | 12.0 ± 0.9 | − |
| P30 | 14.2 ± 1.1 | + | P108 | 12.0 ± 0.3 | − |
| P31 | 14.8 ± 0.9 | + | P109 | 11.9 ± 2.1 | − |
| P32 | 12.4 ± 1.1 | − | P110 | 12.0 ± 0.9 | − |
| P33 | 11.7 ± 1.0 | − | P111 | 13.4 ± 0.3 | + |
| P34 | 13.6 ± 0.9 | + | P112 | 11.6 ± 0.9 | − |
| P35 | 11.5 ± 0.7 | − | P113 | 10.5 ± 0.7 | − |
| P36 | 11.2 ± 0.0 | − | P114 | 12.0 ± 0.9 | − |
| P37 | 12.5 ± 0.7 | − | P115 | 11.6 ± 0.3 | − |
| P38 | 12.4 ± 0.3 | − | P116 | 12.5 ± 0.4 | − |
| P39 | 12.3 ± 0.1 | − | P117 | 10.3 ± 1.0 | − |
| P40 | 13.1 ± 0.1 | + | P118 | 11.4 ± 0.0 | − |
| P41 | 13.6 ± 0.0 | − | P119 | 11.5 ± 0.1 | − |
| P42 | 13.0 ± 0.6 | − | P120 | 12.7 ± 1.0 | / |
| P43 | 14.1 ± 0.7 | + | P121 | 12.5 ± 0.1 | − |
| P44 | 10.7 ± 0.4 | − | P122 | 11.1 ± 0.4 | − |
| P45 | 10.0 ± 1.1 | − | P123 | 10.7 ± 1.0 | − |
| P46 | 12.4 ± 0.9 | − | P124 | 14.3 ± 0.7 | + |
| P47 | 11.2 ± 0.3 | − | P125 | 12.9 ± 1.1 | + |
| P48 | 13.1 ± 1.3 | + | P126 | 13.2 ± 0.3 | + |
| P49 | 10.6 ± 0.9 | − | P127 | 11.1 ± 0.8 | − |
| P50 | 11.1 ± 1.6 | − | P128 | 12.3 ± 0.1 | − |
| P51 | 11.8 ± 0.3 | − | P129 | 12.7 ± 0.4 | / |
| P52 | 13.3 ± 0.1 | + | P130 | 11.5 ± 1.6 | − |
| P53 | 12.5 ± 0.4 | − | P131 | 11.8 ± 1.4 | − |
| P54 | 10.8 ± 0.9 | − | P132 | 12.8 ± 0.0 | + |
| P55 | 13.9 ± 1.8 | + | P133 | 12.6 ± 0.6 | − |
| P56 | 12.9 ± 0.4 | − | P134 | 12.6 ± 0.6 | − |
| P57 | 11.1 ± 1.3 | − | P135 | 13.6 ± 0.6 | + |
| P58 | 11.4 ± 0.6 | − | P136 | 11.9 ± 0.1 | − |
| P59 | 12.6 ± 0.9 | − | P137 | 13.9 ± 0.1 | + |
| P60 | 13.5 ± 0.7 | + | P138 | 10.7 ± 0.4 | − |
| P61 | 13.1 ± 1.0 | − | P139 | 11.4 ± 0.9 | − |
| P62 | 12.9 ± 0.4 | − | P140 | 10.8 ± 0.3 | − |
| P63 | 12.9 ± 1.3 | − | P141 | 12.8 ± 0.3 | − |
| P64 | 12.4 ± 0.0 | − | P142 | 13.8 ± 0.3 | + |
| P65 | 14.5 ± 0.4 | + | P143 | 14.7 ± 0.4 | + |
| P66 | 14.7 ± 0.4 | + | P144 | 10.7 ± 0.4 | − |
| P67 | 13.9 ± 0.1 | + | P145 | 13.1 ± 0.2 | + |
| P68 | 11.8 ± 1.1 | − | P146 | 11.7 ± 1.0 | − |
| P69 | 14.3 ± 0.4 | + | P147 | 13.0 ± 1.1 | + |
| P70 | 12.5 ± 0.4 | − | P148 | 13.5 ± 0.7 | + |
| P71 | 12.1 ± 1.3 | − | P149 | 11.0 ± 1.2 | − |
| P72 | 12.6 ± 0.0 | − | P150 | 11.7 ± 0.4 | − |
| P73 | 13.8 ± 0.3 | + | P151 | 12.5 ± 0.6 | − |
| P74 | 13.7 ± 1.3 | + | P152 | 11.9 ± 0.2 | − |
| P75 | 12.0 ± 0.0 | − | P153 | 11.2 ± 1.3 | − |
| P76 | 13.7 ± 0.7 | + | P154 | 12.8 ± 0.9 | + |
| P77 | 11.5 ± 0.0 | − | P155 | 13.5 ± 0.6 | + |
| Number | Glutamic Acid Concentration (g/L) | Positive and Negative Mutations | Number | Glutamic Acid Concentration (g/L) | Positive and Negative Mutations |
|---|---|---|---|---|---|
| GL−6 | 13.3 ± 0.7 | CK | B36 | 13.7 ± 3.2 | + |
| B1 | 13.8 ± 0.3 | + | B37 | 12.6 ± 0.5 | − |
| B2 | 14.7 ± 0.4 | + | B38 | 10.4 ± 0.8 | − |
| B3 | 13.1 ± 0.4 | − | B39 | 12.9 ± 1.0 | − |
| B4 | 13.9 ± 0.4 | + | B40 | 13.5 ± 1.8 | + |
| B5 | 14.7 ± 0.6 | + | B41 | 11.1 ± 2.7 | − |
| B6 | 12.7 ± 1.0 | − | B42 | 12.6 ± 0.5 | − |
| B7 | 11.6 ± 0.5 | − | B43 | 12.5 ± 2.1 | − |
| B8 | 13.1 ± 1.5 | − | B44 | 10.7 ± 0.4 | − |
| B9 | 12.8 ± 0.3 | − | B45 | 13.2 ± 1.1 | − |
| B10 | 13.2 ± 1.1 | − | B46 | 13.5 ± 2.1 | + |
| B11 | 12.2 ± 0.6 | − | B47 | 10.5 ± 0.7 | − |
| B12 | 14.6 ± 0.6 | + | B48 | 12.2 ± 1.1 | − |
| B13 | 13.0 ± 0.5 | − | B49 | 13.8 ± 2.2 | + |
| B14 | 12.6 ± 0.3 | − | B50 | 12.7 ± 0.1 | − |
| B15 | 12.6 ± 0.6 | − | B51 | 12.1 ± 1.3 | − |
| B16 | 10.8 ± 0.3 | − | B52 | 13.6 ± 1.1 | + |
| B17 | 13.8 ± 0.5 | + | B53 | 14.0 ± 0.57 | + |
| B18 | 13.1 ± 0.6 | − | B54 | 13.0 ± 0.6 | − |
| B19 | 12.0 ± 1.1 | − | B55 | 14.4 ± 0.4 | + |
| B20 | 12.6 ± 0.6 | − | B56 | 14.2 ± 0.1 | + |
| B21 | 12.8 ± 0.2 | − | B57 | 14.8 ± 0.2 | + |
| B22 | 13.0 ± 0.6 | − | B58 | 15.4 ± 0.6 | + |
| B23 | 15.0 ± 0.1 | + | B59 | 14.8 ± 0.2 | + |
| B24 | 11.9 ± 0.1 | − | B60 | 11.5 ± 0.7 | − |
| B25 | 14.4 ± 0.6 | + | B61 | 14.0 ± 0.8 | + |
| B26 | 13.4 ± 0.8 | + | B62 | 12.8 ± 0.2 | − |
| B27 | 14.4 ± 0.8 | + | B63 | 12.5 ± 0.7 | − |
| B28 | 11.9 ± 1.3 | − | B64 | 13.8 ± 1.1 | + |
| B29 | 12.8 ± 0.2 | − | B65 | 13.8 ± 0.3 | + |
| B30 | 11.1 ± 2.4 | − | B66 | 12.7 ± 0.4 | − |
| B31 | 12.8 ± 1.1 | − | B68 | 12.8 ± 0.3 | − |
| B32 | 14.1 ± 0.4 | + | B69 | 14.6 ± 0.6 | + |
| B33 | 13.5 ± 1.3 | + | B70 | 14.7 ± 0.7 | + |
| B34 | 14.2 ± 2.2 | + | B71 | 15.2 ± 0.6 | + |
| B35 | 13.4 ± 2.0 | / | B72 | 15.1 ± 1.0 | + |
| Number | Glutamic Acid Concentration (g/L) | Positive and Negative Mutations | Number | Glutamic Acid Concentration (g/L) | Positive and Negative Mutations |
|---|---|---|---|---|---|
| GL−6 | 13.8 ± 0.6 | parental | P−31 | 11.6 ± 3.7 | − |
| B58 | 15.2 ± 0.2 | CK | P−32 | 14.1 ± 0.7 | − |
| P−1 | 14.3 ± 0.1 | − | P−33 | 13.2 ± 0.3 | − |
| P−2 | 14.4 ± 0.3 | − | P−34 | 13.6 ± 1.4 | − |
| P−3 | 16.9 ± 0.1 | + | P−35 | 14.8 ± 0.3 | − |
| P−4 | 13.6 ± 0.6 | − | P−36 | 11.8 ± 0.5 | − |
| P−5 | 16.2 ± 0.6 | + | P−37 | 13.8 ± 0.6 | − |
| P−6 | 16.1 ± 0.4 | + | P−38 | 13.5 ± 0.1 | − |
| P−7 | 14.8 ± 0.3 | − | P−39 | 13.5 ± 2.1 | − |
| P−8 | 16.1 ± 0.7 | + | P−40 | 12.9 ± 0.4 | − |
| P−9 | 15.4 ± 0.3 | + | P−41 | 12.6 ± 0.5 | − |
| P−0 | 15.1 ± 0.2 | − | P−42 | 11.1 ± 0.6 | − |
| P−11 | 13.2 ± 0.3 | − | P−43 | 10.4 ± 4.8 | − |
| P−12 | 14.7 ± 0.1 | − | P−44 | 12.1 ± 0.7 | − |
| P−13 | 15.9 ± 0.1 | + | P−45 | 15.3 ± 0.5 | + |
| P−14 | 15.5 ± 0.1 | + | P−46 | 15.6 ± 0.2 | + |
| P−15 | 14.2 ± 1.1 | − | P−47 | 14.3 ± 0.4 | − |
| P−16 | 14.4 ± 0.6 | − | P−48 | 14.0 ± 0.0 | − |
| P−17 | 15.5 ± 0.1 | + | P−49 | 14.8 ± 1.1 | − |
| P−18 | 14.8 ± 0.0 | − | P−50 | 14.1 ± 0.7 | − |
| P−19 | 16.0 ± 0.0 | + | P−51 | 13.7 ± 0.7 | − |
| P−20 | 15.0 ± 0.9 | − | P−52 | 13.6 ± 1.1 | − |
| P−21 | 14.8 ± 0.6 | − | P−53 | 13.8 ± 0.3 | − |
| P−22 | 15.4 ± 0.6 | + | P−54 | 12.6 ± 0.9 | − |
| P−23 | 13.9 ± 0.7 | − | P−55 | 11.2 ± 3.4 | − |
| P−24 | 15.1 ± 0.7 | − | P−56 | 11.3 ± 4.1 | − |
| P−25 | 12.8 ± 0.3 | − | P−57 | 12.8 ± 0.3 | − |
| P−26 | 12.2 ± 1.1 | − | P−58 | 13.9 ± 0.6 | − |
| P−27 | 10.2 ± 2.0 | − | P−59 | 13.4 ± 0.9 | − |
| P−28 | 14.1 ± 1.0 | − | P−60 | 14.0 ± 0.9 | − |
| P−29 | 13.4 ± 0.9 | − | P−61 | 15.2 ± 0.2 | + |
| P−30 | 12.8 ± 0.3 | − |
| Number | Glutamic Acid Concentration (g/L) | Positive and Negative Mutations | Number | Glutamic Acid Concentration (g/L) | Positive and Negative Mutations |
|---|---|---|---|---|---|
| GL−6 | 13.7 ± 0.4 | parental | B−11 | 14.1 ± 1.0 | + |
| P17 | 14.2 ± 1.1 | CK | B−12 | 15.1 ± 0.3 | + |
| B−1 | 14.2 ± 0.5 | / | B−13 | 15.2 ± 0.4 | + |
| B−2 | 13.6 ± 1.3 | − | B−14 | 15.2 ± 0.6 | + |
| B−3 | 15.1 ± 0.7 | + | B−15 | 14.2 ± 1.2 | / |
| B−4 | 14.2 ± 0.5 | / | B−16 | 13.5 ± 1.3 | − |
| B−5 | 14.0 ± 0.7 | + | B−17 | 12.6 ± 0.5 | − |
| B−6 | 13.5 ± 0.3 | − | B−18 | 12.6 ± 0.4 | − |
| B−7 | 13.5 ± 1.9 | − | B−19 | 13.6 ± 0.5 | − |
| B−8 | 15.7 ± 0.8 | + | B−20 | 12.9 ± 2.4 | − |
| B−9 | 13.6 ± 0.9 | − | B−21 | 12.1 ± 1.0 | − |
| B−10 | 13.9 ± 0.5 | + | B−22 | 13.0 ± 1.0 | − |
References
- Sano, C. History of glutamate production. Am. J. Clin. Nutr. 2009, 90, 728S–732S. [Google Scholar] [CrossRef]
- Vikramachakravarthi, D.; Kumar, R.; Pal, P. Production of L (+) Glutamic Acid in a Fully Membrane-Integrated Hybrid Reactor System: Direct and Continuous Production under Non-Neutralizing Conditions. Ind. Eng. Chem. Res. 2014, 53, 19019–19027. [Google Scholar] [CrossRef]
- Kanakdande, A.P.; Khobragade, C.N.; Sakharam Mane, R. Ultraviolet induced random mutagenesis in Bacillus amyloliquefaciens (MF 510169) for improving biodiesel production. Fuel 2021, 304, 121380. [Google Scholar] [CrossRef]
- Liu, Y.; Xu, Y.; Wang, D.; Jiang, W. Selection of Zygosaccharomyces rouxii strains resistant to cadmium with improved removal abilities through ultraviolet-diethyl sulfate cooperative mutagenesis. Environ. Sci. Pollut. Res. 2017, 24, 18630–18639. [Google Scholar] [CrossRef] [PubMed]
- Huang, D.; Song, Y.; Liu, Y.; Qin, Y. A new strain of Aspergillus tubingensis for high-activity pectinase production. Braz. J. Microbiol. 2019, 50, 53–65. [Google Scholar] [CrossRef] [PubMed]
- Zhang, X.; Zhang, X.; Xu, G.; Zhang, X.; Shi, J.; Xu, Z. Integration of ARTP mutagenesis with biosensor-mediated high-throughput screening to improve l-serine yield in Corynebacterium glutamicum. Appl. Microbiol. Biotechnol. 2018, 102, 5939–5951. [Google Scholar] [CrossRef] [PubMed]
- Fang, M.; Jin, L.; Zhang, C.; Tan, Y.; Jiang, P.; Ge, N.; Heping, L.; Xing, X. Rapid mutation of Spirulina platensis by a new mutagenesis system of atmospheric and room temperature plasmas (ARTP) and generation of a mutant library with diverse phenotypes. PLoS ONE 2013, 8, e77046. [Google Scholar] [CrossRef]
- An, J.; Gao, F.; Ma, Q.; Xiang, Y.; Ren, D.; Lu, J. Screening for enhanced astaxanthin accumulation among Spirulina platensis mutants generated by atmospheric and room temperature plasmas. Algal Res. 2017, 25, 464–472. [Google Scholar] [CrossRef]
- Ma, X.; Zhang, H.; Lu, X.; Han, J.; Zhu, H.; Wang, H.; Yao, R. Mutant breeding of Starmerella bombicola by atmospheric and room-temperature plasma (ARTP) for improved production of specific or total sophorolipids. Bioprocess Biosyst. Eng. 2020, 43, 1869–1883. [Google Scholar] [CrossRef]
- Hou, J.L.; Zhang, X.Y.; Wang, G.X.; Sun, Z.H.; Du, W.; Zhao, Y.X.; Si, F.; Wang, L.Y.; Xing, X.H.; Wang, Y.F. Novel breeding approach for Japanese flounder using atmosphere and room temperature plasma mutagenesis tool. BMC Genom. 2019, 20, 323. [Google Scholar]
- Liu, B.; Sun, Z.; Ma, X.; Yang, B.; Jiang, Y.; Wei, D.; Chen, F. Mutation Breeding of Extracellular Polysaccharide-Producing Microalga Crypthecodinium cohnii by a Novel Mutagenesis with Atmospheric and Room Temperature Plasma. Int. J. Mol. Sci. 2015, 16, 8201–8212. [Google Scholar] [CrossRef] [PubMed]
- Cui, L.Y.; Wang, S.S.; Guan, C.G.; Liang, W.F.; Xue, Z.L.; Zhang, C.; Xing, X.H. Breeding of Methanol-Tolerant Methylobacterium extorquens AM1 by Atmospheric and Room Temperature Plasma Mutagenesis Combined With Adaptive Laboratory Evolution. Biotechnol. J. 2018, 13, e1700679. [Google Scholar] [CrossRef]
- Hu, Z.C.; Li, W.J.; Zou, S.P.; Niu, K.; Zheng, Y.G. Mutagenesis of echinocandin B overproducing Aspergillus nidulans capable of using starch as main carbon source. Prep. Biochem. Biotechnol. 2020, 50, 745–752. [Google Scholar] [CrossRef] [PubMed]
- Jiang, Y.; Shang, Y.; Li, H.; Zhang, C.; Pan, J.; Bai, Y.; Li, C.; Xu, J. Enhancing transglutaminase production of Streptomyces mobaraensis by iterative mutagenesis breeding with atmospheric and room-temperature plasma (ARTP). Bioresour. Bioprocess. 2017, 4, 37. [Google Scholar] [CrossRef] [PubMed]
- Ottenheim, C.; Nawrath, M.; Wu, J.C. Microbial mutagenesis by atmospheric and room-temperature plasma (ARTP): The latest development. Bioresour. Bioprocess. 2018, 5, 12. [Google Scholar] [CrossRef]
- Shi, F.; Tan, J.; Chu, J.; Wang, Y.; Zhuang, Y.; Zhang, S. A qualitative and quantitative high-throughput assay for screening of gluconate high-yield strains by Aspergillus niger. J. Microbiol. Methods 2015, 109, 134–139. [Google Scholar] [CrossRef]
- Tan, Y.; Fang, M.; Jin, L.; Zhang, C.; Li, H.; Xing, X. Culture characteristics of the atmospheric and room temperature plasma-mutated Spirulina platensis mutants in CO2 aeration culture system for biomass production. J. Biosci. Bioeng. 2015, 120, 438–443. [Google Scholar] [CrossRef]
- Yu, Z.; Shen, X.; Wu, Y.; Yang, S.; Ju, D.; Chen, S. Enhancement of ascomycin production via a combination of atmospheric and room temperature plasma mutagenesis in Streptomyces hygroscopicus and medium optimization. AMB Express 2019, 9, 25. [Google Scholar] [CrossRef]
- Zhang, C.; Qin, J.; Dai, Y.; Mu, W.; Zhang, T. Atmospheric and room temperature plasma (ARTP) mutagenesis enables xylitol over-production with yeast Candida tropicalis. J. Biotechnol. 2019, 296, 7–13. [Google Scholar] [CrossRef]
- Chen, C.; Cui, Z.; Zhao, J.; Li, S.; Ren, X.; Chen, T.; Wang, Z. Improving diacetyl production in Corynebacterium glutamicum via modifying respiratory chain. J. Biotechnol. 2021, 332, 20–28. [Google Scholar] [CrossRef]
- Bott, M.; Niebisch, A. The respiratory chain of Corynebacterium glutamicum. J. Biotechnol. 2003, 104, 129–153. [Google Scholar] [CrossRef] [PubMed]
- Wang, L.; Chen, X.; Wu, G.; Li, S.; Zeng, X.; Ren, X.; Tang, L.; Mao, Z. Improved ε-poly-l-lysine production of Streptomyces sp. FEEL-1 by atmospheric and room temperature plasma mutagenesis and streptomycin resistance screening. Ann. Microbiol. 2015, 65, 2009–2017. [Google Scholar] [CrossRef]
- Gu, L.; Tan, M.; Li, S.; Zhang, T.; Zhang, Q.; Li, C.; Luo, X.; Feng, J.; Zhao, S. ARTP/EMS-combined multiple mutagenesis efficiently improved production of raw starch-degrading enzymes in Penicillium oxalicum and characterization of the enzyme-hyperproducing mutant. Biotechnol. Biofuels 2020, 13, 187. [Google Scholar] [CrossRef] [PubMed]
- Lu, H.; Shangguan, L.; Xia, H.; Song, Q.; Li, P.; Li, K.; Chen, S.; Dai, J. Enzymolysis of fermented corn flour to prepare natural umami flavoring. Chin. Sci. Technol. Food Ind. 2022, 43, 158–166. [Google Scholar]
- Zhang, C.; Li, Y.; Zhu, F.; Li, Z.; Lu, N.; Li, Y.; Xu, Q.; Chen, N. Metabolic engineering of an auto-regulated Corynebacterium glutamicum chassis for biosynthesis of 5-aminolevulinic acid. Bioresour. Technol. 2020, 318, 124064. [Google Scholar] [CrossRef]
- Jin, C.; Huang, Z.; Bao, J. High-Titer Glutamic Acid Production from Lignocellulose Using an Engineered Corynebacterium glutamicum with Simultaneous Co-utilization of Xylose and Glucose. ACS Sustain. Chem. Eng. 2020, 8, 6315–6322. [Google Scholar] [CrossRef]
- Han, X.; Li, L.; Bao, J. Microbial extraction of biotin from lignocellulose biomass and its application on glutamic acid production. Bioresour. Technol. 2019, 288, 121523. [Google Scholar] [CrossRef]
- Zheng, S.; Jiang, B.; Zhang, T.; Chen, J. Combined mutagenesis and metabolic regulation to enhance D-arabitol production from Candida parapsilosis. J. Ind. Microbiol. Biotechnol. 2020, 47, 425–435. [Google Scholar] [CrossRef]
- Varela, C.; Agosin, E.; Baez, M.; Klapa, M.; Stephanopoulos, G. Metabolic flux redistribution in Corynebacterium glutamicum in response to osmotic stress. Appl. Microbiol. Biotechnol. 2003, 60, 547–555. [Google Scholar] [CrossRef]
- Kawahara, Y.; Takahashi-Fuke, K.; Shimizu, E.; Nakamatsu, T.; Nakamori, S. Relationship between the glutamate production and the activity of 2-oxoglutarate dehydrogenase in Brevibacterium lactofermentum. Biosci. Biotechnol. Biochem. 1997, 61, 1109–1112. [Google Scholar] [CrossRef]
- Liu, X. Effects of proteases on L-glutamic acid fermentation. Bioengineered 2019, 10, 646–658. [Google Scholar] [CrossRef] [PubMed]
- Zheng, P.; Liu, M.; Liu, X.; Du, Q.; Ni, Y.; Sun, Z. Genome shuffling improves thermotolerance and glutamic acid production of Corynebacteria glutamicum. World J. Microbiol. Biotechnol. 2012, 28, 1035–1043. [Google Scholar] [CrossRef] [PubMed]
- Li, Z.H.; Chen, N. Study on the Directional Breeding of High Glutamic-Acid Production Strain GTS190 and the Control on its Fermentation. Adv. Mater. Res. 2012, 573–574, 1029–1033. [Google Scholar] [CrossRef]

| Parameters | Operating Conditions |
|---|---|
| Radio frequency power input/W | 120 |
| Illumination distance/mm | 2 |
| aeration rate L/min | 10 |
| Mutagenesis treatment time/s | 20, 40, 60, 80, 100, 120, 140, 160, 180, 200 |
| Sample size | 10 μL (OD600 nm 0.6~0.8) |
| Primers | Sequences (5′–3′) | Uses |
|---|---|---|
| CS-F | TGATTTCCCTCATCCACTCC | Citrate synthetase |
| CS-R | CAGGTTGTGTCCAATGCTTC | |
| ICDH-F | GTCTTTTTCCTCGTCGGTGG | Isocitrate dehydrogenase |
| ICDH-R | ACATCTCCGCTTCTGTTCCA | |
| GDH-F | TCCTTGATTTCGCGGAGCTT | Glutamate dehydrogenase |
| GDH-R | CGCGATTGAAAAGGCTCAGG | |
| ODHC-F | CTTCTTAGCAACGGGAGCCA | Ketoglutarate dehydrogenasecomplex |
| ODHC-R | CGGCCTTGAGACCAACATCT | |
| 16sRNA-F | GTAGGGTGCGAGCGTTGTCC | reference genes |
| 16sRNA-R | CGCCATTGGTGTTCCTCCTG |
Disclaimer/Publisher’s Note: The statements, opinions and data contained in all publications are solely those of the individual author(s) and contributor(s) and not of MDPI and/or the editor(s). MDPI and/or the editor(s) disclaim responsibility for any injury to people or property resulting from any ideas, methods, instructions or products referred to in the content. |
© 2023 by the authors. Licensee MDPI, Basel, Switzerland. This article is an open access article distributed under the terms and conditions of the Creative Commons Attribution (CC BY) license (https://creativecommons.org/licenses/by/4.0/).
Share and Cite
Shangguan, L.; Zhang, H.; Liu, Z.; An, F.; Yang, Q.; Zhang, X.; Yao, L.; Yang, S.; Dai, J.; Chen, X. Improved Glutamic Acid Production Capacity of Corynebacterium glutamicum by the ARTP Mutagenesis Method. Fermentation 2023, 9, 599. https://doi.org/10.3390/fermentation9070599
Shangguan L, Zhang H, Liu Z, An F, Yang Q, Zhang X, Yao L, Yang S, Dai J, Chen X. Improved Glutamic Acid Production Capacity of Corynebacterium glutamicum by the ARTP Mutagenesis Method. Fermentation. 2023; 9(7):599. https://doi.org/10.3390/fermentation9070599
Chicago/Turabian StyleShangguan, Lingling, Huiyan Zhang, Zixiong Liu, Feiran An, Qiao Yang, Xiaoling Zhang, Lan Yao, Shihui Yang, Jun Dai, and Xiong Chen. 2023. "Improved Glutamic Acid Production Capacity of Corynebacterium glutamicum by the ARTP Mutagenesis Method" Fermentation 9, no. 7: 599. https://doi.org/10.3390/fermentation9070599
APA StyleShangguan, L., Zhang, H., Liu, Z., An, F., Yang, Q., Zhang, X., Yao, L., Yang, S., Dai, J., & Chen, X. (2023). Improved Glutamic Acid Production Capacity of Corynebacterium glutamicum by the ARTP Mutagenesis Method. Fermentation, 9(7), 599. https://doi.org/10.3390/fermentation9070599

